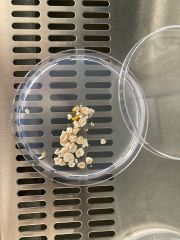

This special page shows all uploaded files.
| Date | Name | Thumbnail | Size | Description | Versions |
|---|---|---|---|---|---|
| 12:24, 12 June 2024 | Sketch 01.png (file) |  |
1.9 MB | 1 | |
| 12:18, 12 June 2024 | Sketch01.pdf (file) | 629 KB | 1 | ||
| 15:25, 15 May 2024 | Chain of Sorrow.png (file) |  |
72 KB | 1 | |
| 15:23, 15 May 2024 | Chain of sorrow.png (file) |  |
45 KB | 1 | |
| 15:43, 27 November 2021 | Bildschirmfoto 2021-11-27 um 12.43.10.png (file) |  |
2.19 MB | File uploaded with MsUpload | 1 |
| 12:50, 27 November 2021 | Biolab vina dois.jpg (file) |  |
352 KB | File uploaded with MsUpload | 1 |
| 12:50, 27 November 2021 | Bildschirmfoto 2021-11-27 um 09.45.24.png (file) |  |
6.82 MB | File uploaded with MsUpload | 1 |
| 22:02, 24 November 2021 | 907B4078.png (file) | Error creating thumbnail: File with dimensions greater than 12.5 MP |
20.15 MB | File uploaded with MsUpload | 1 |
| 15:31, 17 November 2021 | The path created.jpeg (file) | |
254 KB | File uploaded with MsUpload | 2 |
| 15:27, 17 November 2021 | First timelapse.MOV (file) | 2.52 MB | File uploaded with MsUpload | 1 |